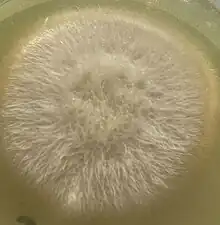

Fusarium
Fusarium est un genre de champignons imparfaits (deutéromycètes).
Les formes parfaites (téléomorphes) de quelques espèces de Fusarium sont connues, et appartiennent à la classe des Ascomycètes (ordre des Hypocréales, famille des Nectriacées, genres Gibberella, Calonectria, et Nectria). Pour plusieurs espèces de Fusarium, le stade parfait demeure inconnu.
Dans ce genre, plusieurs espèces causent une maladie des plantes, dite « fusariose ». Certaines espèces sont impliquées dans des infections opportunistes chez l'homme et chez l'animal. Plusieurs espèces peuvent produire des mycotoxines.
Description
Le principal caractère morphologique des espèces de Fusarium est la présence de macroconidies fusiformes et cloisonnées.
La culture de Fusarium en laboratoire est en général aisée sur les milieux usuels de mycologie (gélose Sabouraud + Chloramphénicol), on obtient des colonies au bout de 3 à 7 jours à 25°C.
Impacts agro-économiques
Le genre Fusarium regroupe plusieurs espèces phytopathogènes susceptibles d’attaquer un grand nombre de plantes, provoquant des maladies appelées fusarioses.
Ces champignons infectent de nombreuses céréales, graminées et autres plantes, et ils survivent dans les graines, dans les résidus de culture et dans le sol. À l'automne, favorisés par les sols humides, ils envahissent le collet, les racines ou les gaines foliaires. À ce stade, ils peuvent provoquer la pourriture des semences et la fonte des semis. Au printemps, ils sont favorisés par les sols secs et la forte concentration d'engrais. Les lésions continuent de s'étendre, donnant lieu à la pourriture du collet, de la tige et des racines.
Les semences pourrissent ou les plantules meurent avant leur levée. Chez les plantules qui lèvent, la croissance est arrêtée et le collet, les racines ou la base de la tige présentent une pourriture allant du brun au brun rouge.
Le champignon se conserve dans le sol grâce à ses chlamydospores et au mycélium capable de survivre sur les débris. La dissémination se fait au niveau du sol par les eaux de ruissellement, le vent ou les éclaboussures ou les importations dans l'exploitation de terreaux ou de plants contaminés.
Certaines espèces saprophytes sont accessoirement capables de se développer en tant que pathogènes secondaires sur des tissus végétaux sénescents.
Exemples

- En Languedoc-Roussillon, une espèce de Fusarium s'est attaqué à l'asperge et a rendu la terre des parcelles touchées impropres à sa culture plusieurs années.
- Au Maghreb, une espèce de Fusarium est responsable du bayoud, maladie du palmier dattier qui a détruit les deux tiers des palmeraies du Maroc.
- Des espèces de Fusarium s'attaquent aussi au blé, à l'orge, au maïs, à l'avoine, à la tomate, au melon, au concombre, à la courgette, au topinambour, au piment, à la pomme de terre, à la patate douce, à la pastèque, au céleri, à l'ail, à l'oignon, au chou, au gingembre, à la banane, au manioc, aux fleurs d’ornement et à beaucoup d’arbres fruitiers.
- À Madagascar, la fusariose détruit chaque année, des centaines d'hectares de plantation de vanille.
- La maladie de Panama ou fusariose du bananier est due à Fusarium oxysporum. Cette maladie tue les bananiers plus ou moins rapidement.
Toxicologie, écotoxicologie
Des champignons du genre Fusarium sont connus pour leur aptitude à synthétiser certaines mycotoxines sur la plante, certaines toxines n'étant synthétisées que par certaines espèces. Les quantités et les types de mycotoxines varient selon les souches de fusarium présents sur les plants. Aujourd'hui, les principales mycotoxines surveillées dans les produits alimentaires sont la déoxynivalénol (DON) et la zéaralénone (ZEA) produites par F. graminearum. On les retrouve à la récolte, dans l’immense majorité des cas en d’infimes quantités (quelques ppm voire ppb), mais des pics de contamination sont parfois observés.
Effets sur l'animal ou l'être humain
Depuis une vingtaine d’années, on sait que certaines espèces de Fusarium sont susceptibles de réaliser de graves infections opportunistes surtout chez les personnes immuno-déprimées. Les spores de Fusarium aéroportées et inhalés, ou ingérées avec la nourriture, peuvent être une source importante de problèmes de santé,
Les symptômes peuvent inclure la nausée, le vomissement, la diarrhée, la dermatite et hémorragie interne. Les spores peuvent se développer sur les yeux (première cause de kératomycose), dans les sinus, sur la peau et les ongles et sont susceptibles de provoquer de la fièvre des foins et l'asthme. Ils causent fréquemment des lésions de la peau chez les patients brûlés, des mycoses des ongles, de l'otomycose, des ulcères variqueux, le mycétome, des ostéomyélites ou des infections disséminées.
Les infections dues aux différentes espèces de Fusarium sont collectivement regroupées sous le terme de « fusarioses ».
Quelques espèces (Fusarium du groupe roseum) peuvent produire de puissantes toxines (mycotoxines), qu'on trouve parfois en concentrations significatives sur des grains ou des produits dérivés. Ingérées par des animaux ou par l'homme, elles peuvent provoquer de graves intoxications alimentaires, éventuellement mortelles, avec risque cancérigène. Ces toxines peuvent affecter les systèmes circulatoire, digestif, cutané et nerveux.
Quelques espèces de Fusarium
- Fusarium euwallaceae
- Fusarium tricinctum
- Fusarium poae
- Fusarium langsethiae
- Fusarium du groupe roseum qui contient les espèces : Fusarium graminearum, Fusarium culmorum, Fusarium arthrosporioides et Fusarium avenaceum, entre autres.
- Fusarium moniliforme variété subglutinans
- Fusarium oxysporum
- Fusarium solani
Espèces de Fusarium pathogènes primaires
- Fusarium solani
- Fusarium avenaceum
- Fusarium culmorum
- Fusarium graminearum
- Fusarium moniliforme
- Fusarium oxysporum
- Fusarium poae
- Fusarium proliferatum
- Fusarium sporotrichioides
- Fusarium subglutinans
- Fusarium tricinctum
Fusarium non pathogènes primaires
- Fusarium acuminatum
- Fusarium equiseti
- Fusarium lateritium
- Fusarium sambucinum
Autre
- Microdochium nivale ou Monographella nivalis var. nivalis
Monographella nivalis var. nivalis ne fait pas partie des Fusarium, mais ce champignon provoque une maladie évoquant la fusariose sur les épis de blé, raison pour laquelle il est souvent confondu avec Fusarium.
Taxinomie
La taxinomie du genre est complexe. Un certain nombre de schémas différents ont été envisagés et jusqu'à mille espèces ont été identifiées à certains moments, selon les concepts de spéciation larges ou étroits adoptés par les auteurs[1],[2],[3].
Les études phylogénétiques indiquent sept clades principaux dans le genre[3].
Subdivisions
Divers schémas ont conduit à subdiviser le genre en sous-genres et en sections. Il existe cependant une mauvaise corrélation entre les sections et les clades phylogénétiques[3]
Les sections précédemment décrites sont notamment :
- Arachnites
- Arthrosporiella
- Discolour
- Elegans
- Eupionnotes
- Gibbosum
- Lateritium
- Liseola
- Martiella
- Ventricosum
- Roseum
- Spicarioides
- Sporotrichiella
Liste d'espèces
Selon Catalogue of Life (8 avril 2017)[4] :
- Fusarium acaciae-mearnsii O'Donnell, T. Aoki, Kistler & Geiser, 2004
- Fusarium aethiopicum O'Donnell, Aberra, Kistler & T. Aoki, 2008
- Fusarium albidum (Rossman) O'Donnell & Geiser, 2015
- Fusarium albosuccineum (Pat.) O'Donnell & Geiser, 2015
- Fusarium alkanophilum Palacios-Prü & V. Marcano, 2001
- Fusarium ananatum A. Jacobs, Marasas & P.S. van Wyk, 2010
- Fusarium andinum Syd., 1939
- Fusarium andiyazi Marasas, Rheeder, Lampr., K.A. Zeller & J.F. Leslie, 2001
- Fusarium anguioides Sherb., 1915
- Fusarium annulatum Bugnic., 1952
- Fusarium anthophilum (A. Braun) Wollenw., 1916
- Fusarium armeniacum (G.A. Forbes, Windels & L.W. Burgess) L.W. Burgess & Summerell, 2000
- Fusarium arthrosporioides Sherb., 1915
- Fusarium asiaticum O'Donnell, T. Aoki, Kistler & Geiser, 2004
- Fusarium austroamericanum T. Aoki, Kistler, Geiser & O'Donnell, 2004
- Fusarium aywerte (Sangal. & L.W. Burgess) Benyon & L.W. Burgess, 2000
- Fusarium azukiicola T. Aoki, H. Suga, F. Tanaka, Scandiani & O'Donnell, 2012
- Fusarium babinda Summerell, C.A. Rugg & L.W. Burgess, 1995
- Fusarium baccharidicola Henn., 1908
- Fusarium bactridioides Wollenw., 1934
- Fusarium begoniae Nirenberg & O'Donnell, 1998
- Fusarium bicellulare Kirschst., 1941
- Fusarium boothii O'Donnell, T. Aoki, Kistler & Geiser, 2004
- Fusarium brachygibbosum Padwick, 1945
- Fusarium brasilicum T. Aoki, Kistler, Geiser & O'Donnell, 2004
- Fusarium brasiliense T. Aoki & O'Donnell, 2005
- Fusarium brevicatenulatum Nirenberg, O'Donnell, Kroschel & Andrianaivo, 1998
- Fusarium bugnicourtii Brayford, 1987
- Fusarium buharicum Jacz. ex Babajan & Teterevn.-Babajan, 1929
- Fusarium bulbicola Nirenberg & O'Donnell, 1998
- Fusarium burgessii M.H. Laurence, Summerell & E.C.Y. Liew, 2011
- Fusarium caeruleum Lib. ex Sacc., 1886
- Fusarium camptoceras Wollenw. & Reinking, 1925
- Fusarium catenulatum F.J. Chen, 2000
- Fusarium caucasicum Letov, 1929
- Fusarium cavispermum Corda, 1837
- Fusarium chlamydosporum Wollenw. & Reinking, 1925
- Fusarium cicatricum (Berk.) O'Donnell & Geiser, 2013
- Fusarium ciliatum Link, 1825
- Fusarium commune K. Skovg., O'Donnell & Nirenberg, 2003
- Fusarium compactum (Wollenw.) Raillo, 1950
- Fusarium concentricum Nirenberg & O'Donnell, 1998
- Fusarium concolor Reinking, 1934
- Fusarium cortaderiae O'Donnell, T. Aoki, Kistler & Geiser, 2004
- Fusarium crassistipitatum Scandiani, T. Aoki & O'Donnell, 2011
- Fusarium crookwellense L.W. Burgess, P.E. Nelson & Toussoun, 1982
- Fusarium culmorum (Wm.G. Sm.) Sacc., 1892
- Fusarium cuneirostrum O'Donnell & T. Aoki, 2005
- Fusarium cyanostomum (Sacc. & Flageolet) O'Donnell & Geiser, 2013
- Fusarium dactylidis T. Aoki, Geiser, P.R. Johnst. & O'Donnell, 2015
- Fusarium denticulatum Nirenberg & O'Donnell, 1998
- Fusarium derridis Henn., 1902
- Fusarium detonianum Sacc., 1886
- Fusarium dimorphum J.V. Almeida & Sousa da Câmara, 1903
- Fusarium discolor Appel & Wollenw., 1910
- Fusarium diversisporum Sherb., 1915
- Fusarium dlaminii Marasas, P.E. Nelson & Toussoun, 1986
- Fusarium dominicanum Cif., 1955
- Fusarium eichleri Bres., 1903
- Fusarium elegans Appel & Wollenw., 1910
- Fusarium elongatum Cooke, 1890
- Fusarium enterolobii P.K.S. Gupta, 1974
- Fusarium eucalypticola Henn., 1901
- Fusarium euonymi Syd. & P. Syd., 1900
- Fusarium euonymi-japonici Henn., 1902
- Fusarium euwallaceae S. Freeman, Z. Mendel, T. Aoki & O'Donnell, 2013
- Fusarium expansum Schltdl., 1824
- Fusarium fijikuroi Nirenberg, 1976
- Fusarium filiferum (Preuss) Wollenw., 1916
- Fusarium flavum (Fr.) Wollenw., 1931
- Fusarium flocciferum Corda, 1828
- Fusarium foetens Schroers, O'Donnell, Baayen & Hooftman, 2004
- Fusarium fractiflexum T. Aoki, O'Donnell & K. Ichik., 2001
- Fusarium fructigenum Fr., 1832
- Fusarium fujikuroi Nirenberg, 1976
- Fusarium gerlachii T. Aoki, Starkey, L.R. Gale, Kistler & O'Donnell, 2007
- Fusarium globosum Rheeder, Marasas & P.E. Nelson, 1996
- Fusarium graminum Corda, 1837
- Fusarium guttiforme Nirenberg & O'Donnell, 1998
- Fusarium haematococcum Nalim, Samuels & Geiser, 2011
- Fusarium hibernans Lindau, 1909
- Fusarium hostae Geiser & Juba, 2001
- Fusarium incarnatum (Desm.) Sacc., 1886
- Fusarium inflexum R. Schneid., 1975
- Fusarium juglandinum Peck, 1909
- Fusarium juruanum Henn., 1904
- Fusarium kelerajum Samuels, Nalim & Geiser, 2011
- Fusarium keratoplasticum D. Geiser, O'Donnell, Short & Ning Zhang, 2013
- Fusarium kurdicum Petr., 1959
- Fusarium kurunegalense Samuels, Nalim & Geiser, 2011
- Fusarium kyushuense O'Donnell & T. Aoki, 1998
- Fusarium lacertarum Subrahm., 1983
- Fusarium lactis Pirotta, 1879
- Fusarium langsethiae Torp & Nirenberg, 2004
- Fusarium laricis Sawada, 1950
- Fusarium longipes Wollenw. & Reinking, 1925
- Fusarium louisianense L.R. Gale, Kistler, O'Donnell & T. Aoki, 2011
- Fusarium lunulosporum Gerlach, 1977
- Fusarium macroceras Wollenw. & Reinking, 1925
- Fusarium mahasenii Samuels, Nalim & Geiser, 2011
- Fusarium mangiferae Britz, M.J. Wingf. & Marasas, 2002
- Fusarium martiellae-discolorioides Batikyan, 1969
- Fusarium meridionale T. Aoki, Kistler, Geiser & O'Donnell, 2004
- Fusarium mesoamericanum T. Aoki, Kistler, Geiser & O'Donnell, 2004
- Fusarium metachroum Appel & Wollenw., 1910
- Fusarium mexicanum T. Aoki, S. Freeman, Otero-Colina, Rodr.-Alv., Fern.-Pav., R.C. Ploetz & O'Donnell, 2010
- Fusarium microcera Bilai, 1955
- Fusarium mindoanum Petr., 1950
- Fusarium miscanthi W. Gams, Klamer & O'Donnell, 1999
- Fusarium moronei Curzi, 1928
- Fusarium musae Van Hove, Waalwijk, Munaut, Logrieco & Ant. Moretti, 2011
- Fusarium musarum Logrieco & Marasas, 1998
- Fusarium napiforme Marasas, P.E. Nelson & Rabie, 1988
- Fusarium nelsonii Marasas & Logrieco, 1998
- Fusarium neoceras Wollenw. & Reinking, 1925
- Fusarium neocosmosporiellum O'Donnell & Geiser, 2013
- Fusarium nepalense T. Aoki, J. Carter, P. Nicholson, Kistler & O'Donnell, 2011
- Fusarium nisikadoi T. Aoki & Nirenberg, 1997
- Fusarium nurragi (Summerell & L.W. Burgess) Benyon, Summerell & L.W. Burgess, 2000
- Fusarium otomycosis Y.N. Ming & T.F. Yu, 1966
- Fusarium oxysporum Schltdl., 1824
- Fusarium pallidoroseum (Cooke) Sacc., 1886
- Fusarium paspali Henn., 1905
- Fusarium peltigerae Westend., 1849
- Fusarium pentaclethrae Henn., 1905
- Fusarium petroliphilum (Q.T. Chen & X.H. Fu) Geiser, O'Donnell, Short & N. Zhang, 2013
- Fusarium phragmiticola Kirschst., 1936
- Fusarium phyllachorae Henn., 1907
- Fusarium phyllophilum Nirenberg & O'Donnell, 1998
- Fusarium phyllostachydicola W. Yamam., 1962
- Fusarium poae (Peck) Wollenw., 1913
- Fusarium polyphialidicum Marasas, P.E. Nelson, Toussoun & P.S. van Wyk, 1986
- Fusarium proliferatum (Matsush.) Nirenberg ex Gerlach & Nirenberg, 1982
- Fusarium pseudensiforme Samuels, Nalim & Geiser, 2011
- Fusarium pseudoanthophilum Nirenberg, O'Donnell & Mubat., 1998
- Fusarium pseudocircinatum O'Donnell & Nirenberg, 1998
- Fusarium pseudonygamai O'Donnell & Nirenberg, 1998
- Fusarium psidii P.K.S. Gupta, 1974
- Fusarium ramigenum O'Donnell & Nirenberg, 1998
- Fusarium ramulicola Sawada, 1959
- Fusarium rectiphorum Samuels, Nalim & Geiser, 2011
- Fusarium redolens Wollenw., 1913
- Fusarium reticulatum Mont., 1843
- Fusarium retusum Wellman, 1943
- Fusarium robustum Gerlach, 1977
- Fusarium rostratum Appel & Wollenw., 1910
- Fusarium rubiginosum Appel & Wollenw., 1910
- Fusarium rusci (Sacc.) O'Donnell & Geiser, 2013
- Fusarium sampaioi Gonz. Frag., 1924
- Fusarium sarcochroum (Desm.) Sacc., 1882
- Fusarium secorum Secor, Rivera-Varas, D.S. Christ, F. Mathew, M.F.R. Khan, Varrelm. & M. Bolton, 2014
- Fusarium setosum Nirenberg & Samuels, 1989
- Fusarium sibiricum Gagkaeva, Burkin, Kononenko, Gavrilova, O'Donnell, T. Aoki & Yli-Mattila, 2011
- Fusarium sinensis Z.H. Zhao & G.Z. Lu, 2008
- Fusarium solani (Mart.) Sacc., 1881
- Fusarium sorghi Henn., 1907
- Fusarium sphaerosporum Q.T. Chen & X.H. Fu, 1987
- Fusarium splendens Matuo & Takah. Kobay., 1960
- Fusarium sporotrichioides Sherb., 1915
- Fusarium sterilihyphosum Britz, Marasas & M.J. Wingf., 2002
- Fusarium stromaticola Henn., 1900
- Fusarium sublunatum Reinking, 1934
- Fusarium subulatum Appel & Wollenw., 1910
- Fusarium succisae J. Schröt., 1892
- Fusarium sulphureum Schltdl., 1824
- Fusarium tasmanicum (McAlpine) Rossman, 1983
- Fusarium temperatum Scaufl. & Munaut, 2011
- Fusarium torreyae T. Aoki, J.A. Sm., L. Mount, Geiser & O'Donnell, 2013
- Fusarium torulosum (Berk. & M.A. Curtis) Nirenberg, 1995
- Fusarium trichothecioides Wollenw., 1912
- Fusarium tritici Erikss., 1891
- Fusarium tupiense C.S. Lima, Pfenning & J.F. Leslie, 2012
- Fusarium ulmicola Dearn. & House, 1940
- Fusarium urticearum (Corda) Sacc., 1886
- Fusarium ussurianum T. Aoki, Gagkaeva, Yli-Mattila, Kistler & O'Donnell, 2009
- Fusarium venenatum Nirenberg, 1995
- Fusarium verrucosum (Pat.) O'Donnell & Geiser, 2013
- Fusarium vogelii Henn., 1902
- Fusarium vorosii B. Tóth, Varga, Starkey, O'Donnell, H. Suga & T. Aoki, 2007
- Fusarium wolgense Rodigin, 1942
- Fusarium wollenweberi Raillo, 1950
Notes et références
Voir aussi
Bibliographie
- Identifier les champignons transmis par les semences, R. Champion, INRA éditions, 1997.
- (en) Common Laboratory Seed Health Testing Methods for Detecting Fungi, S.B. Mathur et Olga Kongsdal, publication ISTA, 2003.
- (en) P E Nelson, M C Dignani et E J Anaissie, « Taxonomy, biology, and clinical aspects of Fusarium species », Clin Microbiol Rev, vol. 7, no 4, , p. 479–504 (PMID 7834602, PMCID 358338).
- (en) Antonio Moretti, « Taxonomy of Fusarium genus: A continuous fight between lumpers and splitters », Zbornik Matice srpske za prirodne nauke, no 117, , p. 7–13 (DOI 10.2298/ZMSPN0917007M, lire en ligne).
- (en) Maiko Watanabe, Takahiro Yonezawa, Ken-ichi Lee, Susumu Kumagai, Yoshiko Sugita-Konishi, Keiichi Goto et Yukiko Hara-Kudo, « Molecular phylogeny of the higher and lower taxonomy of the Fusarium genus and differences in the evolutionary histories of multiple genes », BMC Evolutionary Biology, vol. 11, no 1, , p. 322 (PMID 22047111, PMCID 3270093, DOI 10.1186/1471-2148-11-322, lire en ligne, consulté le ).
Articles connexes
Liens externes
- (en) Référence Catalogue of Life : Fusarium (consulté le )
- (en) Référence Index Fungorum : Fusarium Link 1809 (+ liste espèces) (+ MycoBank) (consulté le )
- http://www.inspq.qc.ca/moisissures/fiche.asp?no=17
- Portail de la mycologie
- Portail de la protection des cultures